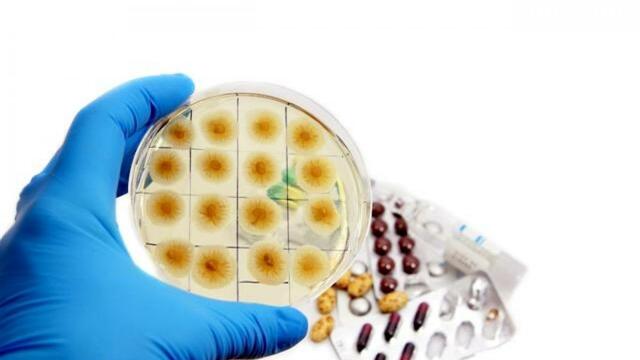
Penicilina

-
Se menciona la trepanación, la circuncisión y extirpación
de tumores superficiales. -
 Realizo múltiples observaciones tanto de clínica como de moral y
Realizo múltiples observaciones tanto de clínica como de moral y
aconsejo la trepanación, el tratamiento expectante de las fracturas abiertas deprimidas, -
 Desarrolló métodos y principios que darían lugar a invenciones como la lógica.
Desarrolló métodos y principios que darían lugar a invenciones como la lógica. -
Con sus estudios anatómicos, funda la anatomía fisiológica y la
anatomía por planos o topográfica. -
Descubrió y demostró la circulación mayor de la sangra, publicando
su obra exercitatio anatomica de Motu Cordis et sanguinis in
animalibus. -
 Vaso que se encuentra en el interior de las vellosidades
Vaso que se encuentra en el interior de las vellosidades
intestinales. -
En anatomía humana, el conducto torácico o ducto torácico es una
parte importante del sistema linfático. -

-
Tuvo la audacia de oponerse a las opiniones que
prevalecían en la época y en la sala de su casa efectuó una cirugía de abdomen en una mujer que sufría de un tumor gigante del ovario. -
 Fue el primero que patento los guantes de goma.
Fue el primero que patento los guantes de goma. -
Utilizo un nuevo método en la amputación de una pierna
del paciente Frederich Chyrchil que se había infectado en una
cirugía previa. -
Descubrió las propiedades analgésicas del cloroformo y
lo comenzó a administrar a sus pacientes en sustitución del éter. -
 Se aísla la cocaína en el laboratorio de wöhler.
Se aísla la cocaína en el laboratorio de wöhler. -
Bier introduce la anestesia intrarraquídea con cocaína
en la cirugía general. -
Se emplea la estobaína en la anestesia raquídea.
-
Alexander Fleming.
Alexander Fleming.
A list shows items. A timeline shows sequence.
Use Timetoast to make dates, milestones, and turning points easier to understand in a clear visual format. Timetoast is a timeline maker for work, school, research, and stories.